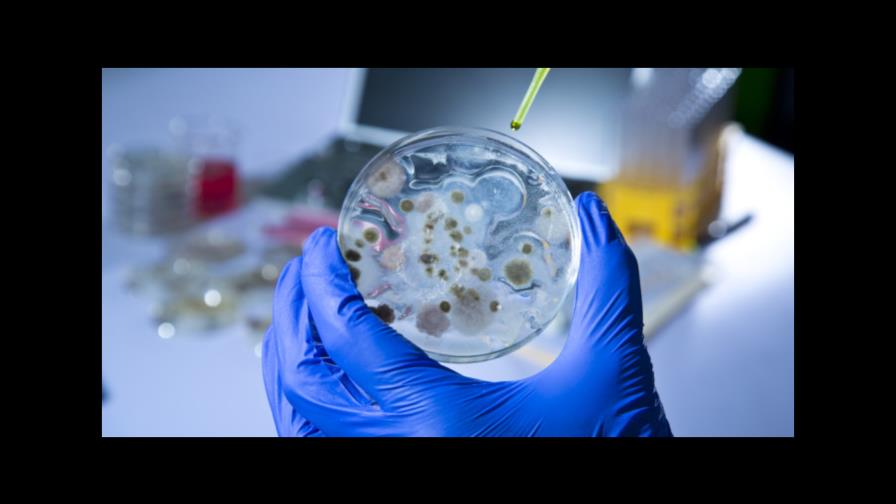
Descubren nanotecnología para superar la resistencia a los antibióticos

Descubren nanotecnología para superar la resistencia a los antibióticos
MADRID. El uso de nanopartículas activadas por la luz -llamadas puntos cuánticos- puede dar un impulso crucial a la eficacia de los tratamientos antibióticos contra superbacterias resistentes a la medicación, entre ellas la E. coli y la salmonela, según un estudio que publica Science Advances.
Expertos de la estadounidense Universidad de Colorado Boulder repotenciaron antibióticos ya existentes para algunas infecciones clínicas mediante el uso de puntos cuánticos tratados con nanotecnología, que pueden ser desplegados de manera selectiva, además de activarlos y desactivarlos usando ondas de luz.
Los puntos cuánticos liberan un superóxido, un compuesto químico que interfiere con los procesos celulares y metabólicos de la bacteria, lo que desencadena un repuesta que la hace más susceptible que el antibiótico original.
Los agentes infecciosos resistentes a los antibióticos son un problema creciente y en Estados Unidos generan un coste directo aproximado de 20.000 millones de dólares en atención médica, recuerda el informe.
Este nuevo enfoque para reactivar los antibióticos que ya no funcionan con algunas bacterias, ataca a esos agentes infecciosos de una manera diferente a cómo se hacía hasta ahora.
Uno de los responsables del estudio, Prashant Nagpal, destacó que “la reacción natural de la bacteria (a los puntos cuánticos) en realidad la hace más vulnerable”.
El uso de puntos cuánticos reduce la resistencia antibiótica efectiva de las infecciones clínicas aisladas por un factor de mil y sin producir efectos secundarios adversos, según el estudio.
Para la otra autora del experimento, Anushree Chatterjee, se trata de una nueva estrategia que “actúa contra la fuerza normal de la infección y cataliza el antibiótico”, según un comunicado del centro universitario.
Otros tratamientos antibióticos han demostrado ser demasiado indiscriminados en su ataque, mientras que el uso de puntos cuánticos tiene la ventaja de poder actuar de manera selectiva a nivel intracelular.
Así, la salmonela puede crecer y reproducirse dentro de las células, pero los puntos cuánticos son lo suficientemente pequeños como para entrar también y ayudar a acabar con la infección desde el interior.
Las bacterias superresistentes a los antibióticos existen especialmente en los hospitales, resaltó Nagpal, que añadió que “están a una mutación de convertirse en infecciones mucho más extendidas”.
La ventaja más importante de uso de la tecnología de los puntos cuánticos es -para Chatterjee- que ofrece a los médicos una estrategia “multidimensional versátil para luchar contra infecciones que están llegando al límite de los actuales tratamientos”.
Y es que “la enfermedades trabajan mucho más rápido que nosotros” y “la medicina también tiene que evolucionar”, consideró el experto.
EFE
EFE